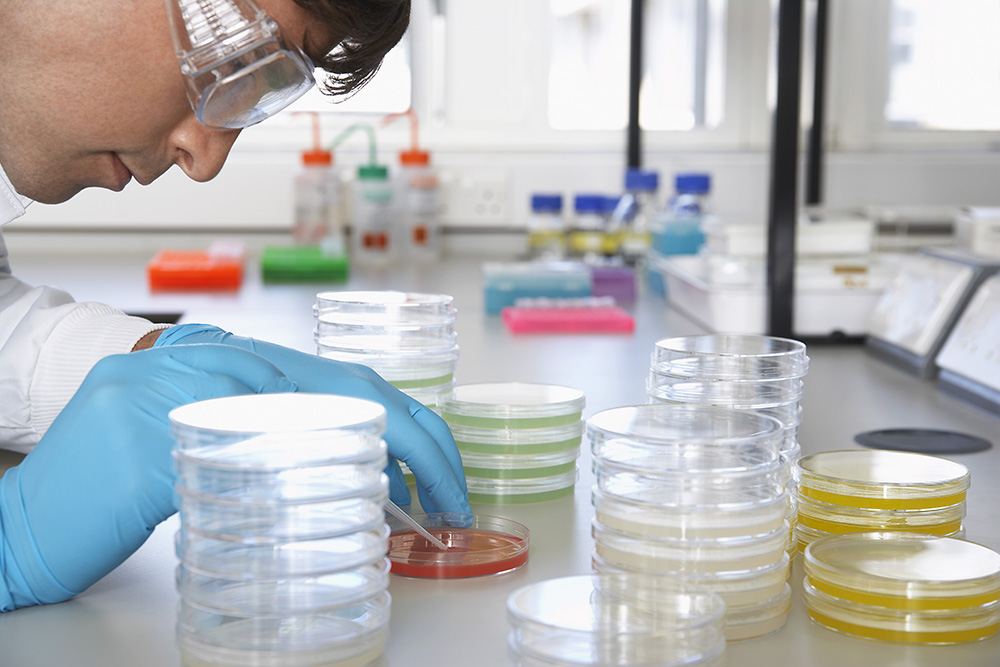
​  Experimental drug shows promise against Alzheimer's disease

Experimental drug shows promise against Alzheimer's disease
03 May 2021 by Ted Escobedo 1 min read
Researchers at Albert Einstein College of Medicine have designed an experimental drug that reversed key symptoms of Alzheimer's disease in mice. The drug works by reinvigorating a cellular cleaning mechanism that gets rid of unwanted proteins by digesting and recycling them. The study was published online on April 22, 2021, in the journal Cell.
Know more: https://www.sciencedaily.com/releases/2021/04/210422150402.htm
5.4 Tuesday: Fitness
- Tags:
- News